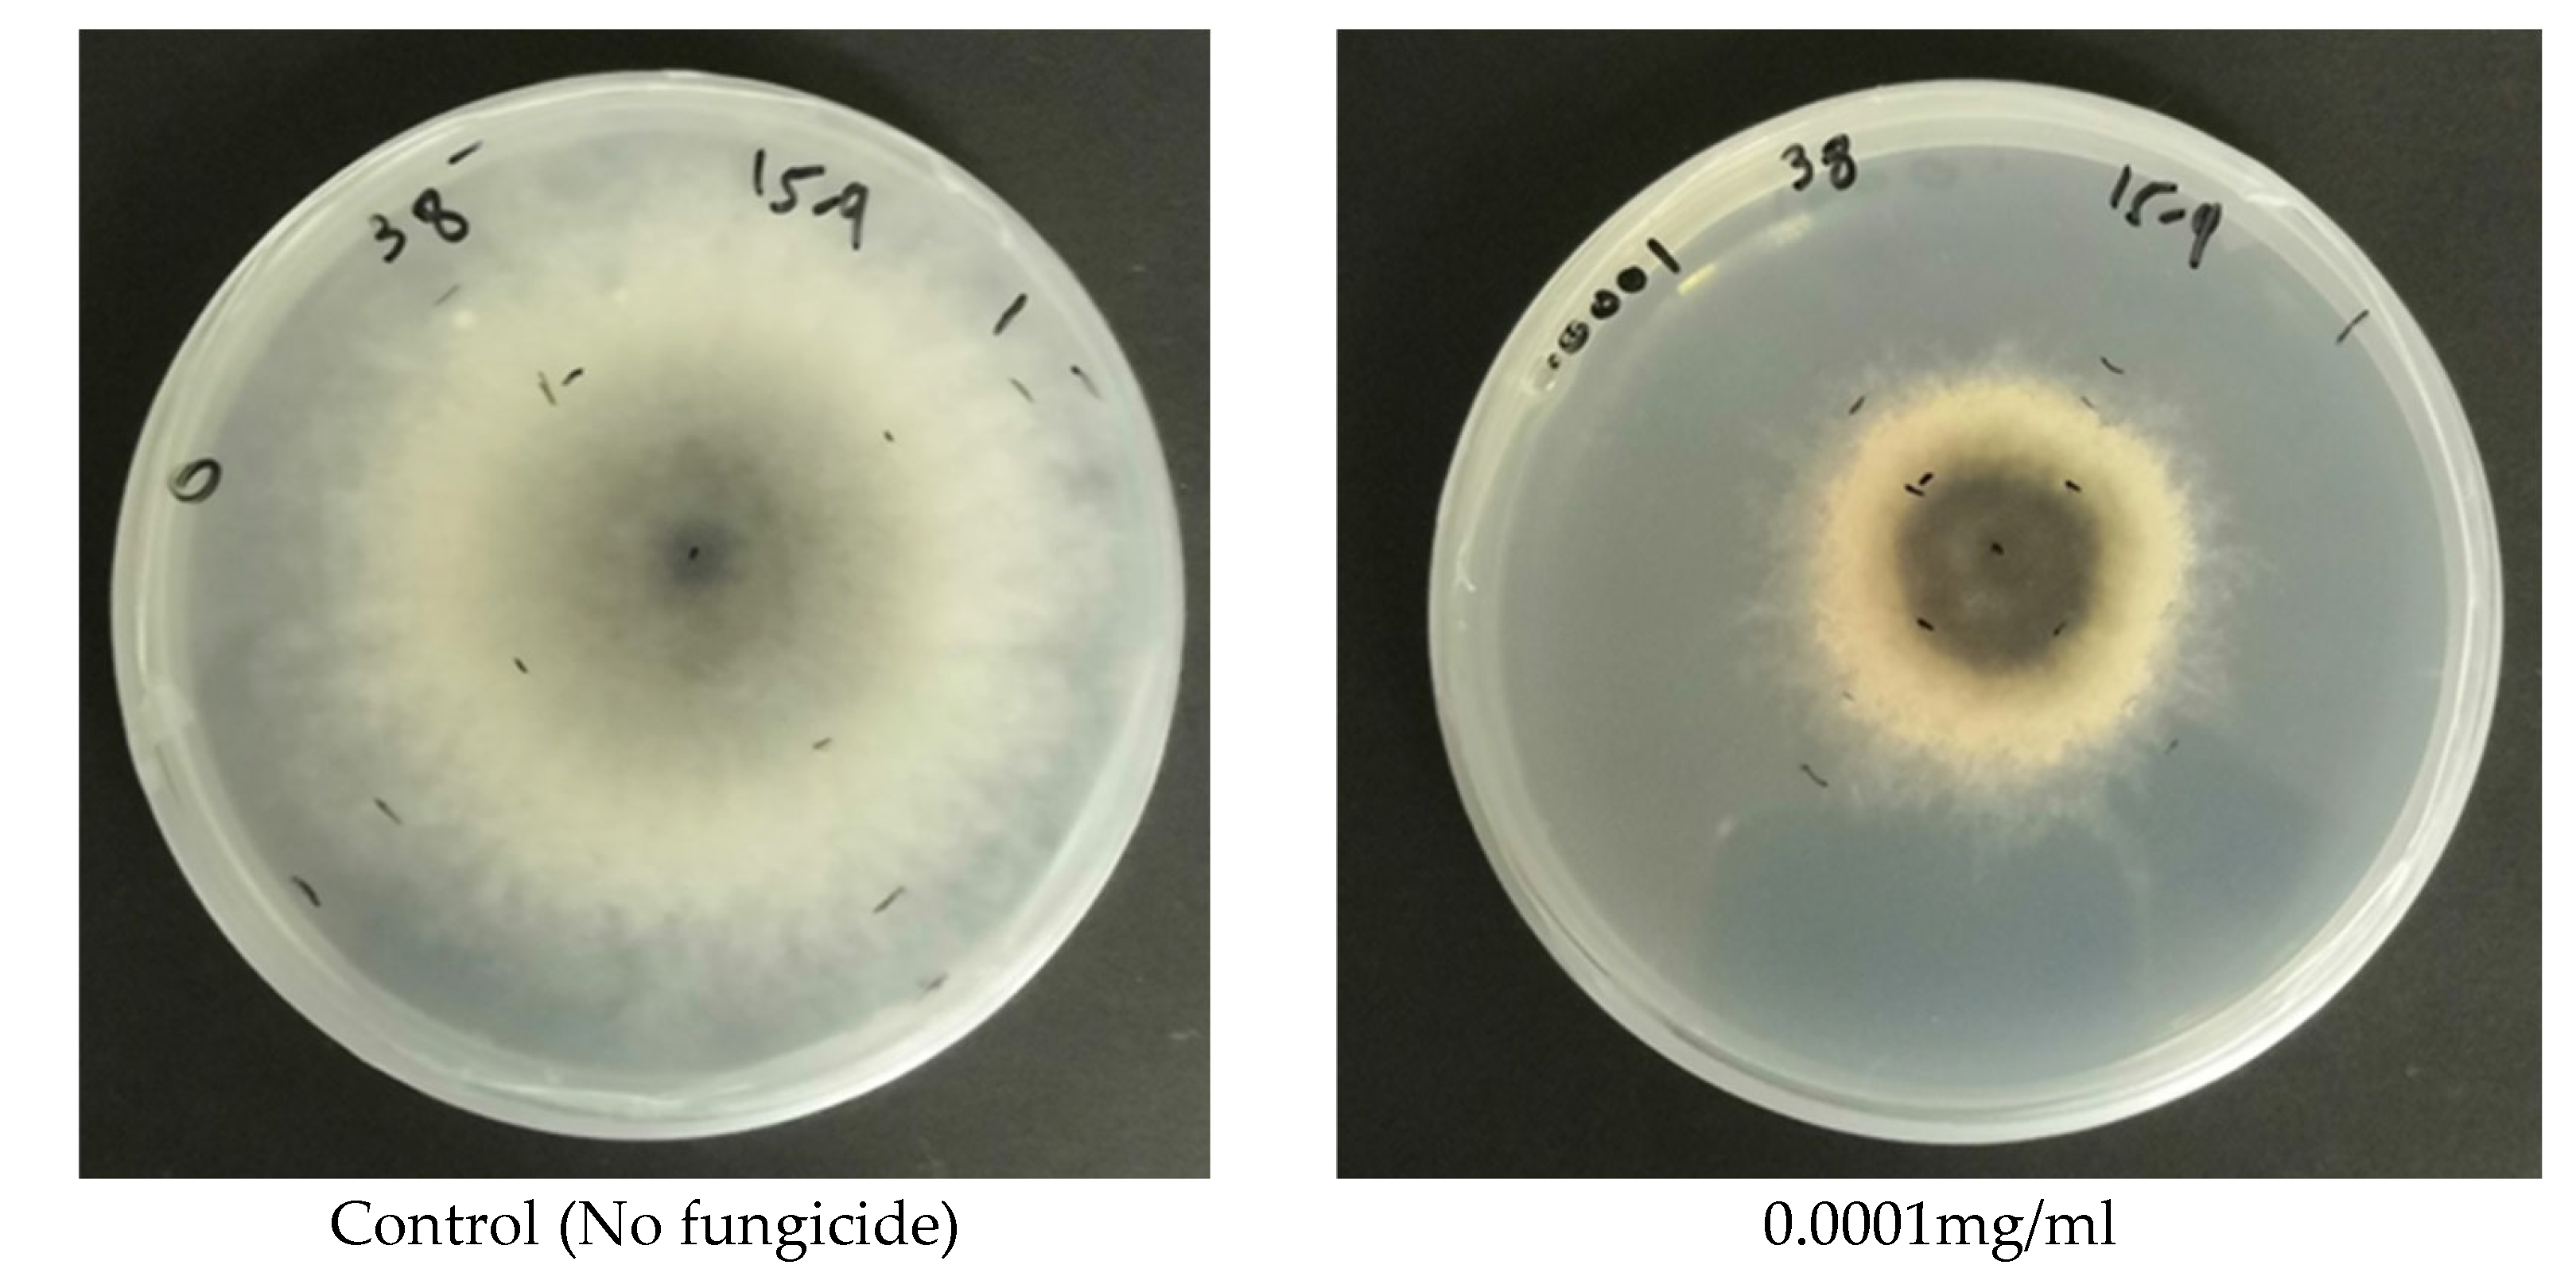
Preprints 197830 g005a
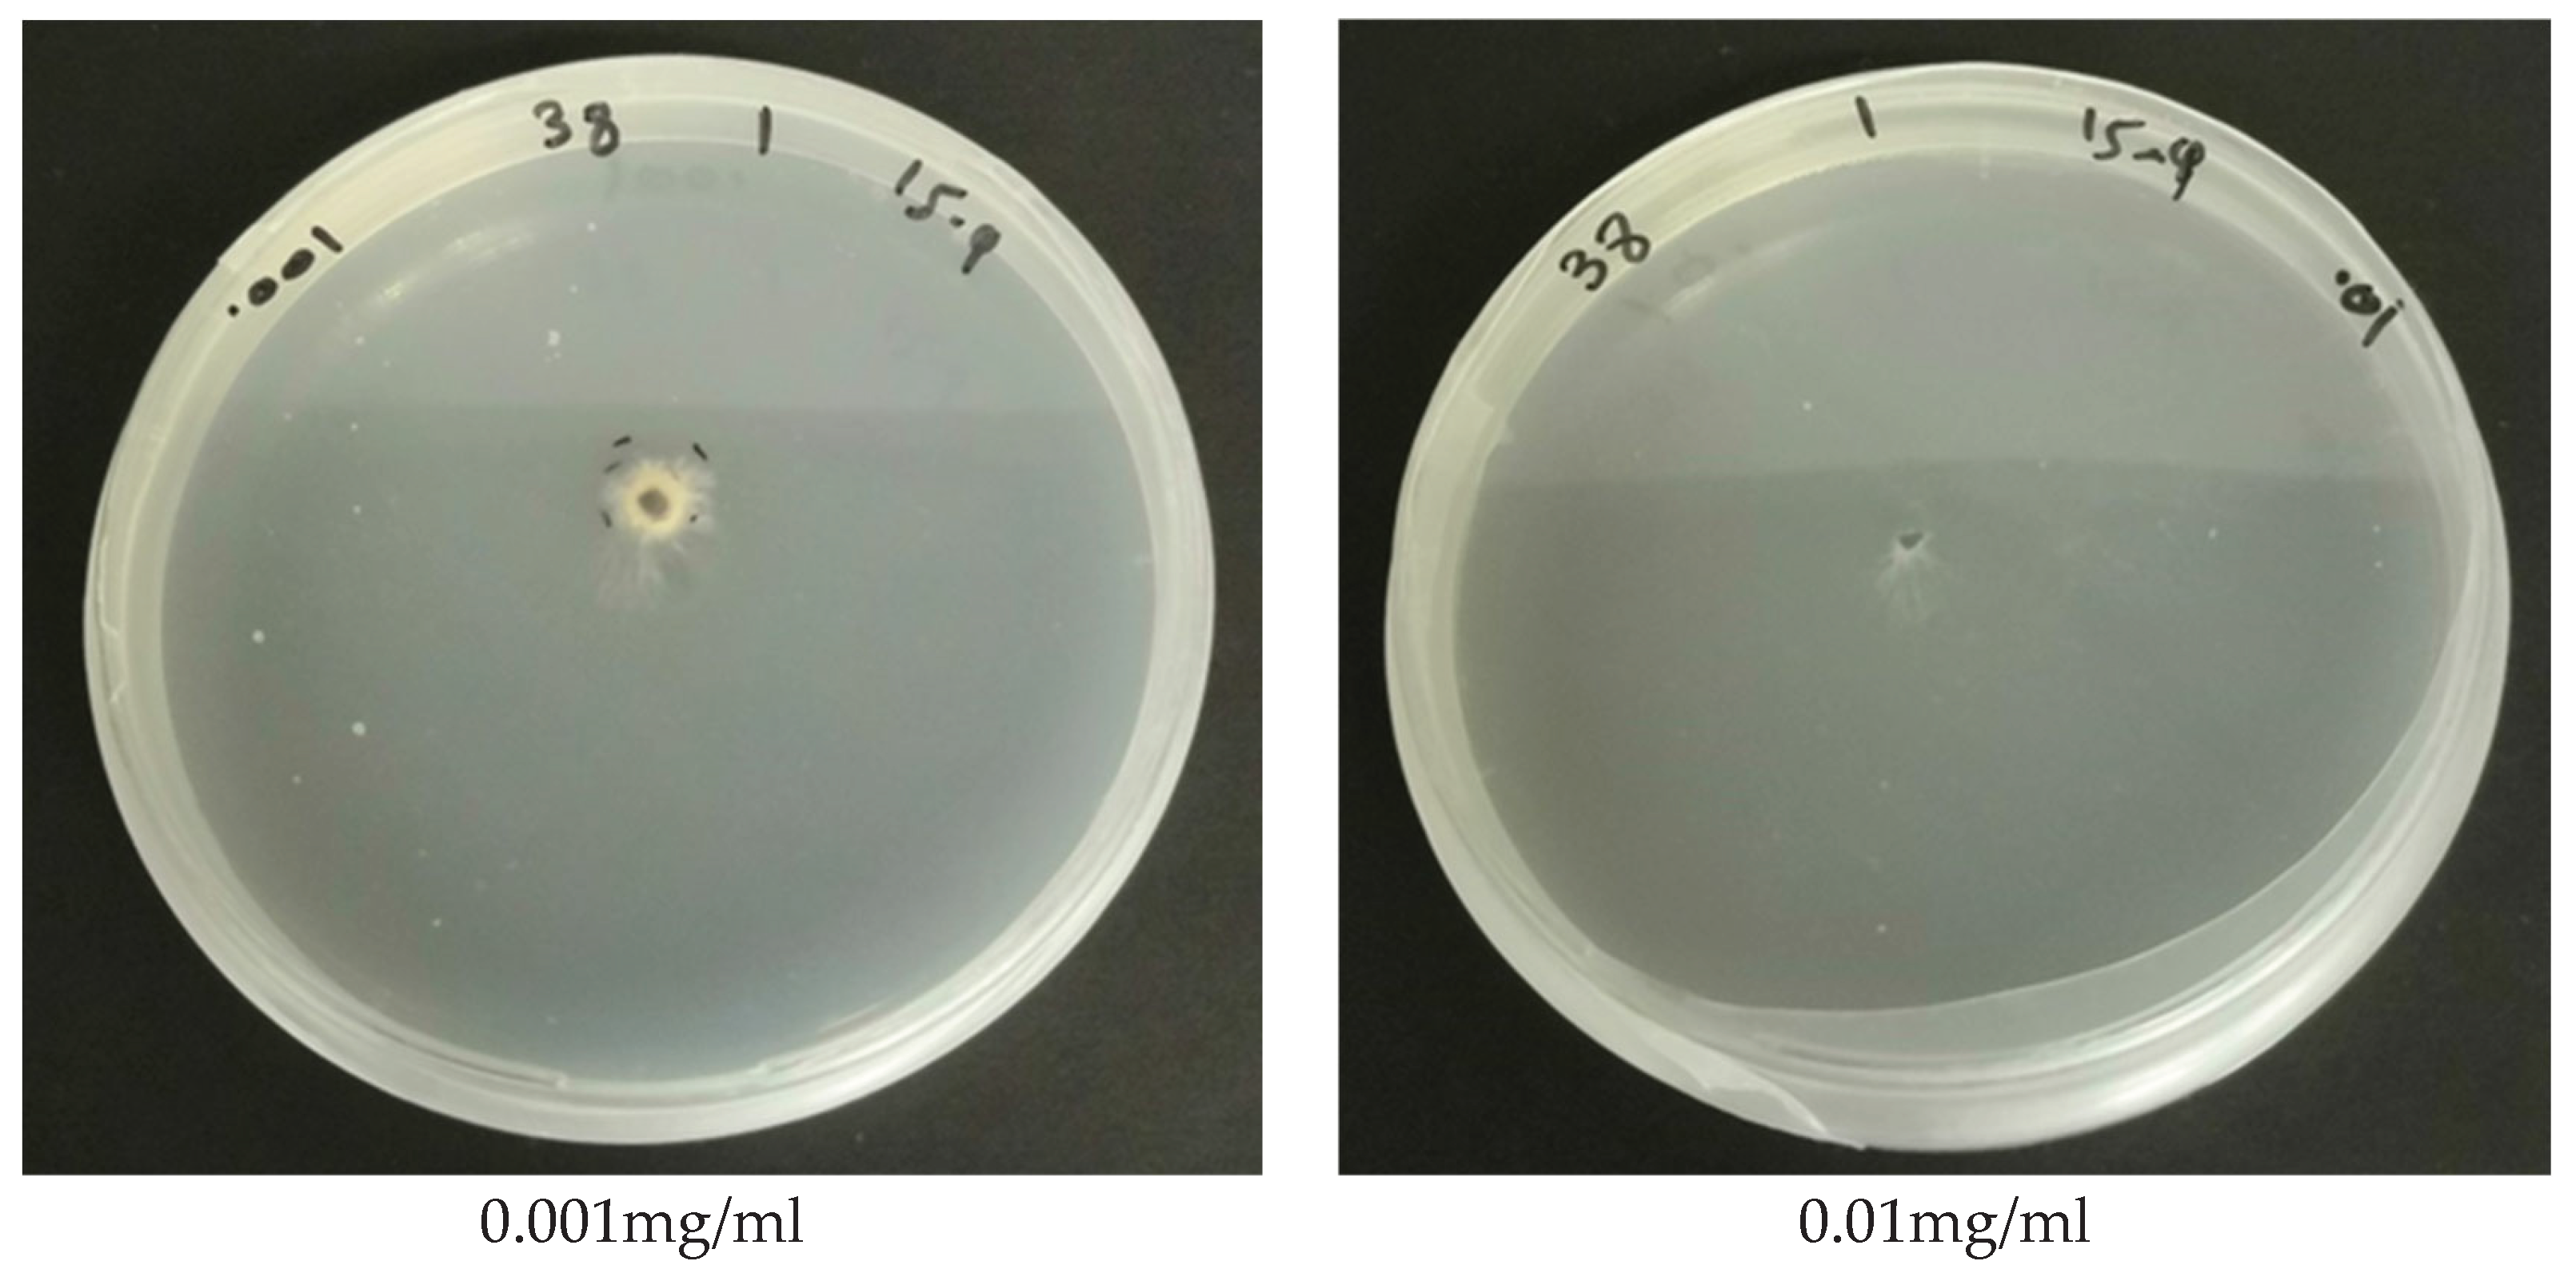
Preprints 197830 g005b

1. Introduction
Stone fruit trees, including Peach (
Prunus persica L. Batsch), Apricot (
Prunus armeniaca (L.) Dumort.), Plum (
Prunus domestica L.), Almond (
Prunus dulcis (Miller) Webb), and Cherries (
Prunus avium L.), are highly significant fruit trees worldwide [
1]. These trees are renowned for their exceptional taste and are considered among the most desirable fruit crops within the category of temperate fruit crops [
1]. The global production of stone fruits exceeded 47 million tons in 2017 [
2]. In the 2024-2025 growing season, the global production of peaches, nectarines, and cherries was estimated at 28.473 million tons [
3].
Stone fruit trees in Jordan are considered major economic crops. The total area cultivated with stone fruit trees is estimated at 4792 ha, from which 3460 ha (163,108 trees) are in Al Mafraq, representing about 72% of the total area planted to stone fruit trees in Jordan [
4]. In Jordan, stone fruit trees suffer from many abiotic and biotic stresses. Abiotic stresses include soil and water salinity, drought, early spring frosts, low winter temperatures, hail, and occasional heat stress during summer. Biotic stresses include many insect-plant pests and plant diseases.
In recent years, farmers in Jordan started to face a new challenge in the production of stone fruit trees, represented by the appearance of dieback symptoms, twig blights, and decline. Mixed infections might cause these symptoms and include interactions between biotic and abiotic stresses. However, many of the symptoms observed worldwide are caused by fungal plant pathogens known as fungal trunk diseases (FTDs) [
5].
Decline and dieback result in a range of symptoms such as shoot and leaves discoloration and distortion, poor growth, cankers, root mortality, wood staining and necrosis, decline, and dieback of the whole plant [
5]. In addition, rapid collapses in twigs and branches in mid-summer with leaf chlorosis that suddenly wilt and die, as well as sunken lesions on the bark of twigs and branches and production of black stroma on some infected shoots or dead wood, have also been reported [
6,
7].
Prunus species may exhibit a characteristic symptom known as “gummosis,” which is observed as oozing gummy substances on the trunk of the infected area (Bush, 2018). Internal symptoms include brown to black vascular streaks that can be visible in cross-sections as circular spots or other shapes of xylem tissue discolorations, with a frequent observation of wedge-shaped necrosis. Infected trees may die within a few weeks after the first symptoms appear, and in later stages, twigs, branches, and shoots wilt and die [
6,
7].
Decline and dieback affecting fruit crops are primarily caused by various fungi that invade the host wood through different types of wounds, subsequently colonizing the vascular tissues [
8]. These wood pathogens induce symptoms such as cankers, gummosis, wood rotting, blight, and dieback [
7]. In severe cases, the dieback of shoots, branches, and main trunks can result in the death of the affected trees [
9]. Numerous fungal pathogens associated with decline and fungal trunk diseases (FTDs) have been identified as species within the families
Botryosphaeriaceae,
Calosphaeriaceae,
Diaporthaceae,
Diatrypaceae,
Nectriaceae,
Phaeomoniellaceae,
Pleosporaceae,
Togniniaceae, and
Valsaceae [
10,
11,
12,
13,
14].
Infection with fungal trunk pathogens is facilitated by wet weather conditions, which can result in spores being dispersed through rain or via insects and humans. The timing of infection is typically in late autumn or early winter and/or late winter or early spring, with the fungi generally penetrating through pruning wounds [
6,
15]. Pathogens responsible for fungal infections can be spread through asymptomatic plant material, seedlings, and fruits, and the avoidance of country and regional quarantine measures can exacerbate the issue [
5].
Control methods for FTD currently focus on removing infected wood, avoiding wounding during or immediately after rains, and using wound protection paints [
16]. In the nursery propagation process, control measures can reduce the risk of producing infected grafted plants [
17]. A recent study [
5] suggests that chemical fungicides are the main strategy for controlling FTD in both nursery propagation material and mature plants in orchards, and pruning wound protection is critical for reducing disease incidence. However, there are few products currently registered for effective control of FTD worldwide, and future research should focus on expanding the range of chemical and alternative options for this purpose [
5].
In Jordan, the decline and dieback of stone fruit trees have emerged as a major threat, affecting numerous stone fruit orchards across the country. Unfortunately, the causes of these diseases remain unknown, as there has been a lack of research on their etiology. Identifying the specific fungal pathogens responsible for decline and dieback in Jordan is crucial to implement effective management strategies. Thus, this research aims to investigate the prevalence of decline and dieback in the major stone fruit-growing region of Jordan, characterize the fungal pathogens at the molecular level, assess their pathogenicity, track the progression of the diseases in inoculated seedlings from the points of inoculation both upwards and downwards, and evaluate the effectiveness of selected fungicides in inhibiting mycelium growth in vitro for selected fungal isolates identified in this study.
3. Discussion
This research represents the first comprehensive study to investigate the diversity and identity of fungal pathogens associated with the decline and dieback diseases of stone fruit trees in Jordan. The current study investigated the incidence and severity of stone fruit tree dieback and decline, as well as the identification of fungal pathogens associated with the disease in Al Mafraq region, which is considered the main production area of stone fruits in Jordan. The Al Mafraq region produces more than 75% of all stone fruits in Jordan [
4].
The results of this study showed that dieback and decline symptoms were prevalent in the surveyed orchards, with the most common symptoms including severe chlorosis, branch dieback, necrotic spots on leaves, leaf defoliation, branch and twig decline, cankers, and gummosis. The high disease incidence and severity of the dieback and decline of stone fruit trees observed in the current study may be attributed to several factors, including the use of infected planting materials, poor orchard management practices, and environmental factors such as drought stress. Further research is needed to investigate the interactions between the identified pathogens and environmental factors in the development of the disease.
The fungal isolates obtained from plant samples collected from the orchards exhibiting dieback and decline symptoms were identified as
Botryosphaeriaceae species (
Neoscytalidium dimidiatum and
Neoscytalidium hyalinum),
Fusarium spp., (
Fusarium proliferatum and Fusarium oxysporum),
Cladosporium oxysporum, and
Valsa sordida based on their morphological and culture characteristics. Molecular identification of fungal isolates using the ITS region of ribosomal DNA and partial sequence of the translation elongation factor (TEF1-α) gene confirmed the primary identification and identified the fungal isolates to the species level. These results are consistent with previous studies that have identified
Botryosphaeriaceae species and
Fusarium spp., as major causal agents of stone fruit tree dieback and decline [
19,
20,
21,
22].
Neoscytalidium dimidiatum has a wide geographical and host range. The symptoms include branch wilt, dieback, canker, leaf blight, gummosis, and tree death. It has been reported on stone fruit trees causing gummosis and decline [
6,
23], on citrus causing shoot blight, canker, and gummosis [
24,
25], on mango causing dieback [
26], and on walnut [
27]. Additionally,
N. dimidiatum has been reported to cause cankers and wilt on a wide range of plant species, such as pistachio and pomegranate [
28],
Ficus religiosa and
Psidium guajava [
29]. Recently, Holland et al. [
22] reported the fungus
Neoscytalidium dimidiatum as one of the most prevalent fungal species causing canker diseases of almond in California. Similarly, Correia et al. [
30] reported the fungal pathogen
Neoscytalidium hyalinum as the causal agent of grapevine dieback in Brazil.
Neoscytalidium hyalinum was reported to cause internal wood lesions, dieback, canker, and decline on willow and poplar trees [
31], on
Calligonum amoenum [
32], on date palm [
33], and melon fruit rot [
34]. To our knowledge, this is the first report on the occurrence of
N. hyalinum on peach causing dieback symptoms on stone fruit trees.
Most of the fungal isolates identified in this study as causal organisms of stone fruit tree decline and dieback belong to the genus
Fusarium, with two species identified,
Fusarium proliferatum and
F. oxysporum.
Fusarium proliferatum has been recently reported by Mannai et al. [
35] as the major cause of peach decline in Tunisian nurseries. These species were also isolated from peach orchards in different countries [
36,
37,
38].
The fungal species
Cladosporium oxysporum was isolated from one field in this study. This fungal species was recently reported to cause leaf blight on one species of stone fruits (
Prunus nepalensis) in India [
39].
The results presented in this study indicate that the fungal isolates obtained from infected trees are pathogenic to peach and apricot seedlings. The inoculated isolates resulted in brown to dark wood discoloration both upward and downward from the point of inoculation within 90-120 days of inoculation. The symptoms observed on the inoculated seedlings included chlorosis, necrotic leaf spots, death of lateral branches, and the presence of gummy exudates on some seedlings. These symptoms are typical of fungal infections, and their presence confirms the pathogenicity of the isolates. The pathogenicity tests also demonstrated that there is variation in the severity of the disease induced by different fungal isolates. Fusarium proliferatum isolates, which constituted more than one-third of the identified pathogens, had the highest mean disease severity across all isolates. These results suggest that Fusarium proliferatum may be a significant pathogen of stone fruit trees’ decline and dieback. Overall, these results have significant implications for the management of fungal diseases in stone fruit tree orchards. The identification of Fusarium proliferatum as a significant pathogen suggests that control measures should be focused on this species.
The results of the study on the in vitro sensitivity of selected fungal isolates causing stone fruit decline to fungicides are significant in identifying potential treatment options for managing this disease. The findings indicate that Azoxystrobin, a Quinone outside inhibitor (QoI), has significant inhibitory effects on the mycelial growth of all fungal isolates tested. Most isolates showed more than 60% inhibition of growth at 1.0 mg of active ingredient per ml of media, which demonstrates the efficacy of Azoxystrobin in controlling the growth of these fungal pathogens. These results agree with Gullino et al., study [
40], which demonstrated that Azoxystrobin was highly effective in providing control for Fusarium wilts of carnation, cyclamen, and Paris daisy when applied at transplant at 1–2 g/m
2 as soil drenching. In contrast, other studies [
41] demonstrated that Azoxystrobin was less effective compared to other fungicides such as a combination of tebuconazole 50% and trifloxystrobin 25% in inhibiting
Fusarium oxysporum due to fungicide resistance to QoI fungicides among
F. oxysporum isolates [
41].
The results of this study also indicate that Pydiflumetofen, a succinate dehydrogenase inhibitor (SDHI) that disrupts mitochondrial respiration, was highly effective in inhibiting the mycelial growth of most of the tested fungal isolates at low concentrations. Results also revealed that the sensitivity to Pydiflumetofen varied among different fungal isolates, with some isolates being particularly sensitive to the fungicide, while others were less sensitive. The high efficacy of Pydiflumetofen at low concentrations observed in this study is encouraging, as it suggests that this fungicide may be a promising option for the control of fungal pathogens causing stone fruit dieback and decline. These results agree with recent studies [
41,
42] that indicated a strong inhibitory activity of Pydiflumetofen against
Fusarium spp., including
F. oxysporum,
Fusarium Fujikuroi [
41] and
F. proliferatum [
43].
Similarly, the fungicide Difenoconazole, a sterol demethylation inhibitor (DMI/sterol biosynthesis), demonstrated significant efficacy against all fungal isolates tested, with even very low concentrations of 0.001 mg a.i/mL being highly effective in inhibiting mycelial growth. Difenoconazole has been reported to have strong inhibitory effects on
Fusarium species pathogens. For example, against
Fusarium fujikuroi and
F. proliferatum isolates, Difenoconazole achieved 100% growth inhibition in vitro, outperforming some other compounds [
44]. Similarly, a mixture of Trifloxystrobin and Tebuconazole achieved 100% growth inhibition of
Fusarium spp. [
44]. In the same study [
44], Azoxystrobin was generally less effective achieving 62 to 100 percent inhibition at different doses of the fungicide. Sterol demethylation inhibitor (DMI) fungicides, including Tebuconazole and Difenoconazole, continue to exhibit substantial activity against multiple
Fusarium species, although sensitivity varies among species, regions, and cropping systems [
45] Similar sensitivity patterns were reported by other studies for
Fusarium species [
46,
47]. Results of this study agree with previous studies [
42,
44] which demonstrated that Difenoconazole, Pydiflumetofen, and Tebuconazole are superior to Azoxystrobin in inhibiting
Fusarium spp., in vitro.
Neoscytalidium dimidiatum is an aggressive woody-plant pathogen with increasing importance in tropical and subtropical regions of the world [
23,
48]. In this study, fungicide sensitivity assays with these pathogens indicate generally high susceptibility to sterol demethylation inhibitor (DMI) fungicides (Tebuconazole and Difenoconazole), as well as high sensitivity levels to the other two fungicides tested (Pydiflumetofen and Azoxystrobin). These results agree with a recent study [
49] that investigated the sensitivity of
Neoscytalidium dimidiatum to DMI fungicides. Karakuş et al., [
49] demonstrated strong inhibition of mycelial growth by Tebuconazole, reporting near-complete growth suppression at recommended concentrations, placing Tebuconazole among the most effective fungicides against
N. dimidiatum [
49].
Similarly, Difenoconazole, either applied alone or in premixed formulations with azoxystrobin, also exhibits high antifungal activity, indicating that sterol demethylation inhibitors (DMIs) are highly effective against this species [
49]. Results of this study agree with Karakuş et al., study [
49], where both Difenoconazole and Tebuconazole were highly effective in inhibiting mycelial growth of both isolates of
Neoscytalidium spp. tested.
Information on the fungicide sensitivity of
Neoscytalidium hyalinum is comparatively scarce, largely due to its historical treatment as a variant of
N. dimidiatum. Available antifungal susceptibility studies indicate that
N. hyalinum isolates tend to be more sensitive to DMI fungicides than pigmented
Neoscytalidium species, suggesting intrinsic differences in membrane sterol metabolism and fungicide uptake [
50,
51].
Cladosporium oxysporum, a dematiaceous fungus associated with leaf and postharvest diseases, generally exhibited high sensitivities to DMI fungicides in this study. Studies on
Cladosporium spp., closely related to
C. oxysporum, indicate that Tebuconazole and Difenoconazole effectively inhibit mycelial growth at low to moderate concentrations, although sensitivity can vary considerably among isolates [
52]. Our results suggest that DMIs, fungicides, Pydiflumetofen, and Azoxystrobin are all effective in inhibiting
Cladosporium oxysporum and might be useful components of chemical control strategies for
C. oxysporum, particularly in integrated programs.
Overall, the results of this study indicate that all four fungicides tested are effective in inhibiting the growth of the fungal isolates causing stone fruit dieback and decline. However, the sensitivity of the isolates varied among the fungicides tested, indicating the need for a tailored approach to fungicide selection based on the specific fungal isolate causing the disease.
It is worth noting that the sensitivity of fungal isolates to different fungicides may change over time due to the development of resistance. Therefore, it is important to use fungicides judiciously and rotate them with other fungicides with different modes of action to prevent the development of resistance in fungal populations. Overall, the results of this study suggest that tested fungicides may be a useful tool for the management of stone fruit dieback and decline caused by sensitive fungal isolates, but further research is needed to determine their efficacy under field conditions and to monitor for the development of resistance.